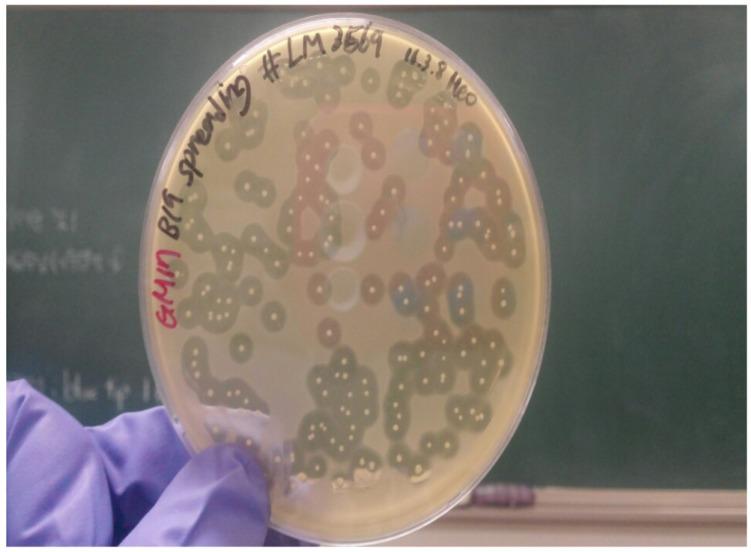
https://cdn.ncbi.nlm.nih.gov/pmc/blobs/c300/5932972/960cfee6630f/kosfa-38-88-f002.jpg

使用噬菌体和产细菌素菌株的抑制作用。 (原英文表述不太准确规范,正常应该是“Inhibition by using Bacteriophages and Bacteriocin Producing Strains.” 翻译为“通过使用噬菌体和产细菌素菌株产生的抑制作用” 但按照你提供的原文翻译如上)
Inhibition of using Bacteriophages and Bacteriocin Producing Strains.
作者信息
Heo Sunhak, Kim Min Gon, Kwon Mirae, Lee Hee Soo, Kim Geun-Bae
机构信息
Department of Animal Science and Technology, Chung-Ang University, Anseong 17546, Korea.
出版信息
Korean J Food Sci Anim Resour. 2018 Feb;38(1):88-98. doi: 10.5851/kosfa.2018.38.1.88. Epub 2018 Feb 28.
In this study, we isolated and characterized a bacteriocin-producing strain and two bacteriophages (P4, A3), showing antimicrobial effects against , from chicken and swine feces by the spot-on-the lawn antagonism method. The selected strain was identified as by 16S rRNA gene sequencing. The bacteriocin from the isolated strain exhibited strong inhibitory activity against four strains of and all the tested strains of , and the bacteriocin were highly heat- and pH-stable even at pH 2, pH 10 and 121℃ for 15 min. We also evaluated the combined effects of the isolated bacteriocin and phages. Combining the phage treatments and bacteriocin resulted in a synergetic effect compared with the phage or the bacteriocin alone. In addition, during the probiotic test, the bacteriocin-producing B19 strain reduced the population of significantly. Treatment with B19 and a cocktail of lytic bacteriophages eradicated the KCTC 3269, completely. Consequently, the isolated bacteriocin and bacteriophages represent candidates for effective biocontrol of , and bacteriocin-producing B19 is a potential probiotic candidate for use in domestic animals.
在本研究中,我们通过琼脂平板点种拮抗法从鸡和猪粪便中分离并鉴定了一株产细菌素的菌株和两种噬菌体(P4、A3),它们对[具体菌种未给出]具有抗菌作用。通过16S rRNA基因测序将所选菌株鉴定为[具体菌种未给出]。从该分离菌株获得的细菌素对四株[具体菌种未给出]和所有测试的[具体菌种未给出]菌株均表现出强大的抑制活性,并且该细菌素即使在pH 2、pH 10以及121℃处理15分钟的条件下仍具有高度的热稳定性和pH稳定性。我们还评估了分离得到的细菌素与噬菌体的联合作用。与单独使用噬菌体或细菌素相比,噬菌体处理与细菌素联合使用产生了协同效应。此外,在益生菌测试中,产细菌素的[具体菌种未给出]B19菌株显著降低了[具体菌种未给出]的数量。用[具体菌种未给出]B19和裂解性噬菌体混合物处理可完全根除[具体菌种未给出]KCTC 3269。因此,分离得到的细菌素和噬菌体是对[具体菌种未给出]进行有效生物防治的候选物,并且产细菌素的[具体菌种未给出]B19是用于家畜的潜在益生菌候选物。